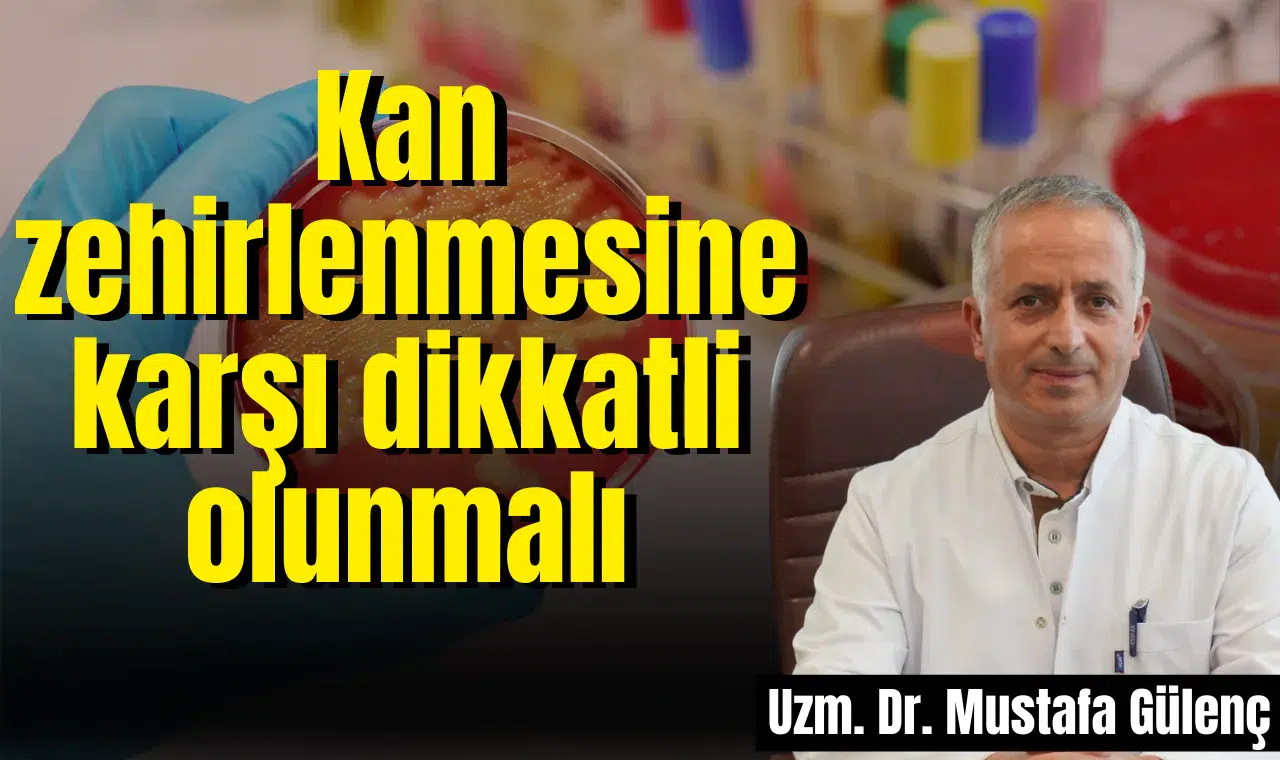
Kan zehirlenmesine karşı dikkatli olunmalı

Manisa Özel Grandmedical Hastanesi Enfeksiyon Hastalıkları Uzmanı Dr. Mustafa Gülenç, “kan zehirlenmesi” olarak adlandırılan sepsisin toplumda yeterince bilinmeyen ancak ölümcül sonuçlara yol açabilen bir sağlık sorunu olduğunu belirtti. Gülenç, “Sepsis özellikle bağışıklık sistemi zayıf olan bireyler, yaşlılar, bebekler ve kronik hastalığı olanlar için büyük bir risk oluşturur” dedi.

Sepsisin vücudun bir enfeksiyona karşı aşırı tepki vermesi sonucu ortaya çıktığını belirten Manisa Özel Grandmedical Hastanesi Enfeksiyon Hastalıkları Uzmanı Dr. Mustafa Gülenç, “Sepsis bakteriyel, viral veya mantar kaynaklı bir enfeksiyonun vücudun savunma sistemini aşırı derecede harekete geçirmesiyle gelişir. Bu süreçte bağışıklık sistemi enfeksiyonla savaşırken sağlıklı dokulara da zarar verebilir ve organ yetmezliklerine yol açabilir” diye konuştu. Sepsisten korunmanın en önemli yolunun enfeksiyonları önlemekten geçtiğini kaydeden Uzm. Dr. Gülenç, “Bu konuda basit ama etkili yöntemler var. Ellerinizi düzenli yıkamak, hijyen kurallarına uymak, açık yaraları temiz tutmak, gerekli aşıları yaptırmak ve kronik hastalıkların tedavisini aksatmamak sepsisi önlemede kritik rol oynar” ifadelerini kullandı.

ERKEN TEŞHİS HAYATKURTARIYOR
Sepsisin erken tanısının hayat kurtardığını belirten Uzm. Dr. Gülenç, dikkat edilmesi gereken belirtileri anlatırken, “Yüksek ateş, hızlı kalp atışı, nefes darlığı, bilinç bulanıklığı, ciltte soğukluk veya morarma gibi şikâyetler sepsis habercisi olabilir. Bu belirtileri yaşayanların zaman kaybetmeden acil servise başvurması gerekir. Erken teşhisle birlikte uygun antibiyotik tedavisi ve destek tedavileri başlatıldığında hayatta kalma şansı çok yükselir” şeklinde konuştu. Toplumun sepsis konusunda bilinçlenmesinin önemini de vurgulayan Uzm. Dr. Mustafa Gülenç, sözlerini şöyle sürdürdü: “Sepsis her yıl milyonlarca insanı etkileyen ama doğru müdahale ile önlenebilir ve tedavi edilebilir bir tablodur. Manisa Özel Grandmedical Hastanesi olarak erken tanı ve etkili tedavi protokollerimizle hastalarımıza en hızlı şekilde müdahale ediyoruz. Vatandaşlarımızı da bu konuda bilinçlenmeye ve risk belirtilerini ciddiye almaya davet ediyoruz.”



HABER: HABER MERKEZİ